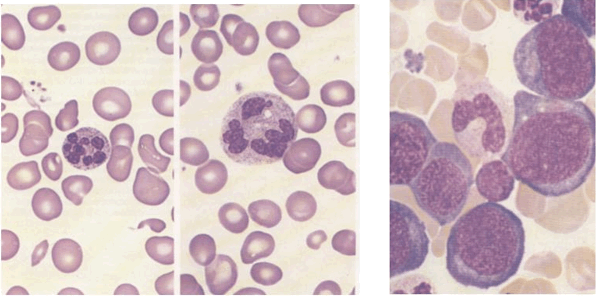
Рассмотрена взаимосвязь железодефицитной анемии с потерей слуха

Эффективность раннего обнаружения анемии.
Добавил пользователь Валентин П. Обновлено: 07.01.2026
Анемия, или малокровие - болезненное состояние, характеризующееся уменьшением концентрации гемоглобина и в подавляющем большинстве случаев числа эритроцитов в единице объема крови. Анемия возникает во все периоды жизни человека не только при различных заболеваниях, но и при некоторых физиологических состояниях, например, при беременности, в период усиленного роста, кормления грудью. Важное социальное значение имеет проблема анемий у детей раннего возраста, так как анемия в этом возрасте может привести к нарушениям физического развития и обмена железа. Развитие анемии может быть связано с периодом полового созревания и климактерическим периодом, гормональными нарушениями, характером питания, заболеваниями пищеварительного тракта, печени, почек, нарушением всасывания, аутоиммунными состояниями, оперативным вмешательством и другими факторами. Нередко анемия является самостоятельным или сопутствующим симптомом многих внутренних заболеваний, инфекционных и онкологических болезней.
Общими симптомами для всех форм анемий являются бледность кожных покровов и слизистых оболочек, одышка, сердцебиение, а также жалобы на головокружение, головные боли шум в ушах, неприятные ощущения в области сердца, резкую общую слабость и быструю утомляемость.
Как можно узнать, есть ли у меня анемия?
Большое значение в диагностике анемии имеет лабораторное исследование крови - определение концентрации гемоглобина, количества эритроцитов, величины и насыщенности их гемоглобином.
Точное определение типа и причины анемии является основанием для выбора правильного лечения. Сравнительная легкость диагностики анемии часто приводит к необоснованному применению "антианемических" средств без выяснения причины и механизма развития анемии.
Такое лечение, как правило, малоэффективно, а в ряде случаев даже приносит вред больному. Несвоевременная диагностика анемии или стирание ее клинических проявлений вследствие лечения без установления причины анемии могут привести к позднему распознаванию ряда серьезных заболеваний; поэтому, в случае выявления анемического состояния необходимо придерживаться следующего правила: вначале нужно установить характер и причину анемии и только после этого назначить соответствующее лечение.
Как еще может проявляться анемия?
Другими симптомами анемии, в первую очередь вследствие недостатка железа в организме являются:
-Ломкость ногтей
Очень важным элементом, обеспечивающим нормальную жизнедеятельность различных тканей человеческого организма, является железо. Если в силу каких-либо причин запас железа организме снижается, то данное обстоятельство сразу проявляет себя повышенной ломкостью ногтей.
-Утончение и ломкость волос.
Для обеспечения нормального развития и роста волос кроме витаминов необходим и такой элемент как железо. Недостаточное содержание железа в организме человека очень быстро приводит к утончению волос и развитию их повышенной ломкости.
-Необычное желание есть мел, глину, зубную пасту, сырые макароны?
При снижении в организме человека запасов железа нарушается нормальная работа особых белков, что приводит к изменению вкусового восприятия пищи и появления необычных пищевых пристрастий.
-Начинает нравиться запах масляной краски, жидкости для снятия лака с ногтей, бензина и керосина?
Для обеспечения механизма восприятия запахов необходимы особые чувствительные клетки-рецепторы. Работа этих рецепторов в значительной степени зависит от содержания в организме человека железа. Уже при незначительном снижении запаса железа работа рецепторов существенно изменяется.
Из-за чего возникает железодефицитная анемия?
Кровопотеря является важнейшей причиной развития железодефицитной анемии. Основной причиной у женщин являются менструальные кровопотери. Срок появления признаков анемии зависит от запасов железа в организме женщины.
Кровопотери из желудочно-кишечного тракта являются второй по частоте причиной железодефицитной анемии у женщин и самой частой причиной у мужчин. В развитии железодефицитной анемии наиболее значимы длительные кровотечения с небольшим объемом суточной кровопотери (10 - 20 мл/сут). Такие кровотечения могут очень длительно оставаться незаметными для пациента, поскольку лишь изменяют окраску стула на более темную.
Третьей по значимости группой причин развития железодефицитной анемии является повышенная потребность в железе. В этой группе особое внимание следует уделить повышенной потребности в железе во время беременности и кормлении грудью.
Основной запас железа человек получает во время внутриутробного развития через плаценту от своей матери и после рождения с материнским молоком. За период вынашивании беременности и лактации женщина расходует более 800 мг железа. Период беременности и лактации требует наличия адекватных запасов железа в организме женщины.
Недостаточное или однообразное питание является еще одной причиной развития анемии. В большинстве случаев отмечается недостаточное поступление в организм железа (железодефицитные анемии), белка, что нарушает образование белковой части гемоглобина (белково-дефицитные анемии). Определенное значение в развитии дефицитных анемий имеет и недостаточность таких витаминов, как В6, В12 и фолиевой кислоты (витаминодефицитные анемии), которые участвуют в синтезе гемоглобина. Нередко дефицитные анемии отмечаются при заболеваниях, сопровождающихся нарушением всасывания в кишечнике. Развитию дефицитных анемий способствуют частые заболевания, а также недоношенность.
Как лечится анемия?
Лечение заключается в устранении причин заболевания, нормализации питания и режима, назначении соответствующих препаратов: например при железодефицитной анемии - препаратов железа (сорбифер дурулеса и др).
В каких продуктах больше всего железа?
Такие продукты, как мясо, зеленые яблоки и гранаты содержат большее количество железа по сравнению с другими.
Будьте здоровы!
Эффективность раннего обнаружения анемии.
Эффективность раннего обнаружения анемии.
Очевидно, что раннее обнаружение и лечение железной недостаточности при отсутствии симптомов существенно уменьшает вред от этих заболеваний, хотя обнаружение анемии может вскрыть наличие других заболеваний, например, скрытых злокачественностей; не существует информации, чтобы предположить, что тестирование на анемию — эффективный способ контроля за такими заболеваниями.
Современные исследователи имеют хорошо развитые тесты для детей, помогающие им определить нужное количество железа для исправления железной недостаточности. Раннее обнаружение анемии может быть полезно в течение беременности. Эпидемиологические исследования связывают низкий гемоглобин у матери с плацентной гипертрофией, преждевременными родами, сжатием плода и младенческой смертью. Неясно из этих исследований, каким образом анемия вызывает все эти осложнения, или насколько она более существенна, чем другие причины, такие, как плохое питание или низкий социально-экономический статус, которые также могут привести к печальным последствиям.
Невысока вероятность того, что анемия у матери вызывает анемию у плода. Кроме того, большинство клинических опытов показывает, что железотерапия эффективна для восстановления числа кровяных телец, не улучшает вес при рождении, продолжительность беременности или другие параметры. Некоторое сокращение гемоглобина у матери в течение беременности является нормальным физиологическим фактором, связанным с возрастанием объема сосудов. Вмешательство для восстановления гемоглобина до значений, имевших место до беременности, может иметь определенные побочные эффекты. С другой стороны, обнаружение анемии может привести к выявлению причин, могущих вызвать осложнения при родах.
Многие организации предлагают различные способы обследования на анемию в детстве. Канадские ученые высказываются за измерение гемоглобина у недоношенных детей, у рожденных от многократно рожавших или страдающих железной недостаточностью женщин и прочих, имеющих низкий социально-экономический статус. Тест рекомендуется проводить при рождении и в возрасте 9 месяцев. Американская академия педиаторов рекомендует проводить подсчет гемоглобина или гематокритного числа по меньшей мере 1 раз в течение беременности. Аналогичные рекомендации по общему или выборочному обследованию детей дают и другие экспериментаторы. Обследование старших детей и подростков поддерживается меньшим числом специалистов. ААП рекомендует по меньшей мере одно обследование в возрасте 1 —4, 5—12 и 16—20 лет.

Канадские ученые не поддерживают обследований на анемию детей за исключением случаев подростковой беременности.
Обследование на анемию у взрослых является предметом обсуждения. Некоторые ученые предлагают проводить обследования на анемию каждые 5 лет, Институт медицины рекомендует производить измерение гематокритного числа по меньшей мере 1 раз в возрасте от 40 до 59 лет, с 60 до 74 лет и после 75 лет. Другие авторы возражают против обязательного обследования беременных женщин на показатели гемато-крита, если только они не являются иммигрантами из слаборазвитых стран. Пренатальное обследование на анемию рекомендуется канадскими учеными, Американским колледжем акушеров и гинекологов и другими.
Заболеваемость анемией среди всего населения относительно низка. Хотя она распространена в некоторых группах риска, небольшая бессимптомная анемия может привести только к небольшим отклонениям. Поэтому, несмотря на наличие надежных методов обследования, нельзя сказать, что тестирование на анемию является необходимым. Наличие некоторых форм анемии, не связанных с недостаточностью железа, например, вызванных недостаточностью витамина 3 или фолиевой кислоты, может привести к тяжелым последствиям, но эти заболевания слишком редки. Не поддерживается мнение об обследовании на анемию для определения сопутствующих заболеваний. Обследование разумно проводить у детей и беременных женщин, которым может быть полезно раннее исправление анемии.
Общее обследование на анемию при отсутствии клинических проявлений рекомендуется только для беременных женщин и детей. Анализы на гемоглобин должны быть сделаны всем женщинам в первый пренатальный визит. Дальнейшее пренатальное тестирование не является необходимым для бессимптомных женщин с низкой вероятностью медицинских или родовых осложнений. Все дети должны быть обследованы. Хотя капиллярные анализы крови легче брать у детей, венозная кровь дает более точную и надежную информацию. Дальнейшие гематологические исследования и диетологические консультации должны быть проведены для всех лиц с обнаруженной анемией.
Информация на сайте подлежит консультации лечащим врачом и не заменяет очной консультации с ним.
См. подробнее в пользовательском соглашении.
Анемия
Это один из основных результатов циркуляции крови - она доставляет молекулы О2 в ткани по артериям и, благодаря венозному оттоку, выводит отработанные материалы, в том числе и углекислый газ. Основной газообмен происходит в альвеолах - конечных образованиях бронхиального дерева. Это та часть дыхательной системы, где кровь отдает одни газы и забирает другие. Недостаточность этого процесса приводит к гипоксии - сниженному поступлению кислорода в ткани. Это сказывается на всех процессах в организме, состоянии тканей и клеточного механизма. Без присутствия кислорода не проходят химические реакции и не происходит энергообмен.
Внешне это проявляется различными клиническими признаками:
- бледность;
- слабость;
- учащенной сердцебиение и дыхание - организм пытается компенсировать недостаток кислорода;
- возможность потери сознания;
- снижение работоспособности;
- мелькание “мушек” перед глазами;
- головокружение;
- шум в ушах;
- раздражительность;
- одышка.
Эти признаки - причина обратиться в медицинский центр для сдачи анализов. Анемия нередко является проявлением патологии, так как сама по себе, чаще всего, она - симптом. Полноценное обследование покажет причину состояния и позволит начать эффективное лечение.
Классификация анемий
Различают несколько видов анемий, в зависимости от происхождения и патогенеза развития. Понимание характера анемии позволит определить тактику лечения, так как различные виды этой патологии имеют разный источник происхождения. Даже общий анализ крови при разных анемиях несколько отличается - для этого необходимо учитывать не только количество эритроцитов и гемоглобина, но и цветной показатель, размер эритроцитов, гематокрит и другие параметры исследования. В некоторых случаях требуется более детальное обследование пациента, клиническая диагностика, для того, чтобы точно сказать, что послужило причиной заболевания.
Рассмотрим подробнее виды анемий и причины их возникновения.
Железодефицитная анемия встречается довольно часто, так как дефицит железа наблюдается у многих людей в мире. Развитие анемии зависит от степени этой недостаточности. Недостаток желез может возникнуть при его нехватке в пище, при повышенном расходовании железа организмом, а также при некоторых особенностях пищеварительного тракта, когда железо не усваивается полностью. Именно сниженное количество железа приводит к развитию 70% всех анемий, так что все остальные причины приходятся только на 30% этой патологии. Основа патогенеза - нарушение образования гемоглобина, основную роль в котором играет молекула железа. Сниженное количество белка, который переносит кровь, отражается на состоянии организма. Недостаточность кислорода имеет общие признаки анемий, но при дефиците железа еще некоторые специфические симптомы - выпадение волос, появление проблем с ногтями, ухудшение работы сердца, пищеварительного тракта. Иногда появляются искаженные вкусовые предпочтения - желание есть мел или краски. Это все возникает по причине недостатка железа. Заболевание чаще наблюдается у детей, женщин во время беременности, пожилых пациентов. Лабораторная диагностика железодефицита подразумевает проведение анализа на белки крови, которые переносят железо, способность сыворотки крови связывать микроэлемент и другие показатели, которые дополняют обычную диагностическую программу при анемии.
В12-дефицитная анемия встречается при недостатке в организме соответствующего витамина, который содержат продукты животного происхождения, в частности, мясо. Это объясняет тот факт, что заболевание часто возникает у тех, кто отказался от употребления таких продуктов. Этот витамин - основной участник образования новых форменных элементов крови - эритроцитов. Причина патологии может заключаться в эндогенных факторах - например при дефиците фактора Касла. Это белок, который вырабатывается клетками слизистой оболочки желудка и способствует потребление витамина организмом из пищи. Анемия может возникнуть после оперативного лечения, в ходе которого удаляется часть кишечника или желудка. Может быть и дефицит витамина в пище. Как правило, определенный запас вещества в организме рассчитан на несколько лет, что объясняет тот факт, что развитие анемии происходит постепенно даже после изменения пищевых привычек. Причиной может стать воспалительный процесс в тканях желудочно-кишечного тракта, прием некоторых медикаментозных средств, нарушение транспорта витамина из крови в внутриклеточное пространство, а также повышенный расход витамина организмом. Кроме общих симптомов анемии, дефицит витамина В12 вызывает язвы на слизистой рта, нарушение иннервации, которое проявляется ухудшением чувствительности, покалываниями и онемением, нарушением памяти и мышления. Дополнительный анализы подразумевают оценку количества витамина в организме, исследование патологий, которые приводят к его дефициту. Специфическим будет и лечение - оно заключается в дополнительном употреблении витаминных препаратов, нормализации состояния органов пищеварения. Витамин В12 участвует не только в формировании эритроцитов - его функции в организме разнообразны, что отражается в множественных осложнениях анемии, если не проводить коррекцию состояния.
Фолиеводефицитная анемия развивается в результате дефицита фолиевой кислоты - витамина, который так же, как и В12 участвует в формировании новых эритроцитов. Фолиевая кислота также называется витамин В9. Недостаток этого вещества в организме возникает при сниженном потреблении продуктов, которые его содержат, иногда это происходит на фоне злоупотребления алкоголем. Нарушение всасывания витамина наблюдается при патологии пищеварения, во время учащенного мочеиспускания, на фоне приема препаратов, которые замедляют метаболизма витамина В9. Повышенный расход фолиевой кислоты сопровождает онкологические заболевания, нарушения кроветворной функции, инфекционную патологию. Симптомы гипоксии при этом виде анемии дополняются нарушениями стула, онемением в мышцах рук и ног, слабостью мышечной ткани, искажением вкусового восприятия, эмоциональной лабильностью. Лабораторная диагностика фолиеводефицитной анемии включает в себя такие специфические методы, как исследование уровня вещества, а также витамина В12. Кроме лабораторных анализов необходимо уточнить причину развития такого состояния, для чего проводят инструментальные исследования. Установление причины сделает лечение более эффективным и ускорит его результат. Осложнения анемии включают в себя недостаток других элементов крови, возникновение множества язвенно-некротических процессов, тошноту и рвоту, снижение иммунной защиты организма.
Постгеморрагическая анемия, если перевести дословно, означает, что состояние развилось после кровотечения и связанной с ним кровопотери. Нарушение целостности сосудов - причина внутренних и внешних кровотечений. В зависимости от интенсивности процесса и скорости потери крови развивается анемия - нехватка эритроцитов и, соответственно, недостаток транспорта кислорода. Это можно определить по клиническим признакам - после кровопотери человек становится бледным, чувствует слабость и шум в ушах. Конечно, легче определить кровопотерю, когда она явно сопровождается видимым вытеканием крови. Но, в некоторых случаях, процесс бывает не таким очевидным. Речь идет о внутренних кровотечениях, которые могут возникать в органах пищеварения, мочеполовой сфере, органах дыхания. Определить их получается не так быстро, для этого требуются методы диагностики, включая инструментальные и лабораторные. Если кровопотеря проходит в короткий срок - это более опасно для организма, нарушаются жизненно важные функции. Постгеморрагическая анемия происходит либо после потери значительного объема циркулирующей крови, либо при постоянном поражении кровеносных сосудов, что чаще всего бывает во внутренних органах.Причиной может стать значительное хирургическое вмешательство, патологические менструации, травма, патология пищеварительного тракта. Определить механизм возникновения анемии в данном случае можно по характерным признакам в общем анализе крови, а также благодаря детальному обследованию организма.
Мегалобластная анемия объединяет патологии, связанные с дефицитом фолиевой кислоты и витамина В12. В анализе крови это отображается повышением цветового показателя - при других видах анемии этого не происходит. Повышается концентрация гемоглобина в каждом эритроците, появляются мегалобласты в костном мозге, увеличивается размер эритроцитов. В сыворотке крови можно наблюдать повышение концентрации железа.
Гемолиз - процесс разрушения эритроцитов, в результате которого возникает соответствующая, гемолитическая анемия. Разрушение эритроцитов приводит к образованию билирубина - крайне токсического вещества, которое способно привести к интоксикации организма. Такая анемия бывает врожденной и приобретенной. Врожденная склонность к гемолизу сопровождает мутации внутриутробного развития, генетические патологии. Приобретенная патология бывает на фоне инфекционного процесса, нарушения работы печени, приема некоторых лекарственных средств, переливания несовместимой крови. Распознать гемолитическую анемию на клиническом этапе можно по таким признакам: желтушный цвет кожи, судороги, повышение температуры, увеличение в размерах печени и селезенки. Диагностика включает в себя лабораторные и инструментальные методы, которые подтвердят специфичность анемии и укажут на её причину. В зависимости от причины возникновения гемолиза подбирается тактика лечения, поэтому так важно установить, что привело к такому состоянию.
Гипопластическая анемия - заболевание, при котором нарушен синтез всех форменных элементов крови. Иногда может встречаться только дефицит эритроцитов. В любом случае наблюдается гипоксия, нарушение транспорта кислорода в ткани. Этот вид анемии также может быть врожденным или приобретенным. Среди причин можно выделить генетические мутации, воздействие радиации, химиотерапии, отравление некоторыми веществами, лекарствами. Клинические проявление при гипопластической анемии возникают постепенно и очень медленно. Кроме обычных симптомов анемии можно выделить снижение иммунитета, возникновение множественных воспалительных, гнойных, некротических процессов, медленное заживление ран, частые простуды. Могут быть кровоизлияния при незначительном повреждении сосуда, кровотечения. Необходимо исследование внутренних органов, лимфатических узлов, костного мозга. Апластическая анемия имеет характерную клиническую картину, специфические изменения в анализах. Лечение проводится сильнодействующими препаратами, а иногда нужны и оперативные методы. Основным моментом является своевременность начала лечения - чем раньше его начать, тем лучше показатели выздоровления и прогноз.
Анемии возникают при хроническом течении инфекционных, онкологических и воспалительных патологий. Могут быть связаны с нарушением синтеза железа, сокращением жизни эритроцитов, повышенным потреблением некоторых веществ, хроническими кровопотерями. Необходимо определить вид анемии, что возможно с помощью лабораторного исследования, а также установить причину её возникновения. Лечение основного заболевания можно дополнить восполнением дефицита определенных веществ, что ускорит процесс выздоровления и улучшит качество жизни пациента. Хроническое течение патологии подразумевает медленное возникновение симптоматики. Это говорит о том, что необходимо внимательно относиться к изменениям со стороны различных органов и систем и своевременно обращаться за медицинской помощью. Если симптомы тревожат длительное время - необходимо пройти полноценную и разностороннюю диагностику.
Современные методы диагностики анемии
Для диагностики анемий используются лабораторные и инструментальные методы исследования. Для правильного лечения важно определить не только сам факт анемии и её вид, но и причину такого состояния. Обнаружение болезни лучше проводить на ранних стадиях процесса и делать это с помощью разнообразных методов диагностики. Полноценная картина состояния организма дает более полное понимание патологии. Только после качественного обследования можно назначить эффективное лечение.
Основной метод диагностики анемии - общий анализ крови. с его помощью можно определить количество эритроцитов и гемоглобина, их соотношение, цветовой показатель, гематокрит, диаметр эритроцитов и другие показатели. Иногда, о причине патологии могут сказать другие показатели общего анализа крови - уровни остальных клеток крови, СОЭ. Этот анализ сдается в первую очередь при подозрении на анемию. В зависимости от его результатов назначаются другие методы диагностики.
Биохимическое исследование крови позволит определить уровень сывороточного железа, белков, которые его переносят, количество витаминов В12 и В9. Именно биохимический анализ помогает вычислить уровень билирубина и его фракций. таким образом, эта манипуляция требуется для уточнения вида анемии. Анализ позволяет оценить большинство процессов в организме, дает исчерпывающую информацию о работе внутренних органов.
Исследование свободного протопорфирина в эритроцитах определяет свойство эритроцитов переносить кислород и позволяет определить причины возникновения анемии. Нарушение связывания гема наблюдается при острых интоксикациях и может быть обнаружено с помощью данной методики.
Анализ пункции костного мозга показывает наличие бластов - предшественников клеток крови. Диагностика применяется для подтверждения или исключения апластической анемии. Кроме того, необходимо откорректировать уровни других недостающих клеток. Исследование сочетается с другими методами диагностики. Раннее начало лечения улучшает прогноз для пациента и возможно только после качественной диагностики.
Исследование кислотности желудочного сока (рН-метрия) необходимо для диагностики железодефицитной анемии. Необходимо определить, по какой причине нарушается всасывание железа в кишечнике и для этого проводится данная диагностика. Повышенная продукция желудочного сока негативно сказывается и на других функциях организма, приводит к хроническому изменению слизистой оболочки вызывает вторичные нарушения.
Наличие в организме паразитов приводит к повышенному расходованию большинства полезных веществ и может провоцировать возникновение анемии. Их поиски также входят в программу диагностики анемий. Именно глисты могут спровоцировать развитие мегалобластной, железодефицитной анемий. Кроме того, паразитарная инфекция негативно сказывается на остальных органах и системах, приводит к хроническому нарушению многих функций.
Исследование кала на скрытую кровь позволяет определить кровопотерю, за счет которой возникает постгеморрагическая анемия. Также, потеря крови - это признак патологии ЖКТ, которую необходимо обнаружить и пролечить. Если медлить с поиском причины анемии - болезнь может прогрессировать, а чем более поздняя стадия процесса - тем сложнее его лечить.
Рентгенологическое и эндоскопическое исследование необходимо для обнаружения источника кровотечения, которое привело к анемии. Это обследование позволяет найти патологию, которую необходимо корректировать не только для лечения анемии, но и для полноценного здоровья организма.
Причины пройти диагностику в АО «СЗЦДМ»
Лаборатория центра оснащена новейшим диагностическим оборудованием. Анализы выполняются быстро и качественно. В штате медицинских центров работают высококвалифицированные специалисты, что позволяет сделать диагностику разносторонней и эффективной. Пациент может не только установить факт анемии, но и пройти расширенную проверку организма, а также лечение. Для наших врачей нет заболевания отдельной системы - они оценивают полноценное состояние пациента и лечат его, а не патологию.
Направления

Гематология Диагностика и лечение заболеваний крови Подробнее
Рассмотрена взаимосвязь железодефицитной анемии с потерей слуха
Рассмотрена взаимосвязь железодефицитной анемии с потерей слуха
Исследователи обнаружили достоверную взаимосвязь между железодефицитной анемией и потерей слуха, включая нейросенсорную тугоухость, проведя оценку медицинских карт более чем 300 000 взрослых людей.
Кэтлин М. Шиффер (Kathleen M. Schieffer), бакалавр хирургии в Медицинском колледже Университета штата Пенсильвания (Херши, штат Пенсильвания, США), и ее коллеги исследовали возможную взаимосвязь двух явлений, используя данные пациентов Медицинского центра Милтон С. Херши при Университете штата Пенсильвани и (Херши, штат Пенсильвания, США). Железодефицитная анемия определялась низкими уровнями гемоглобина и ферритина, согласно возрасту и полу, среди 305 339 взрослых пациентов в возрасте от 21 до 90 лет.
Анализ подтвердил повышенную вероятность существования нейросенсорной тугоухости и смешанной потери слуха у взрослых людей с железодефицитной анемией.
“Исследователи отметили, что существует взаимосвязь между железодефицитной анемией у взрослых людей и потерей слуха. Следующим шагом будет понять эту взаимосвязь и выяснить, смогут ли своевременная диагностика и лечение железодефицитной анемии положительно повлиять на общее состояние здоровья взрослых людей с потерей слуха.
Исследование, проведенное Шиффер К.М. (Schieffer K.M.) и соавторами, было опубликовано в журнале JAMA Otolaryngology-Head & Neck Surgery.
Мнение специалиста:
Железодефицитная анемия представляет собой распространенное и легко излечимое заболевание у обследованных пациентов. Более детальное понимание взаимосвязи между железодефицитной анемией и всеми типами потери слуха может помочь открыть новые возможности для раннего обнаружения и соответствующего лечения сопутствующих патологий.

Аэрозоли – один из путей заражения персонала в лаборатории
В настоящее время считается, что на 1000 сотрудников лабораторий ежегодно приходится около трех случаев заражения.

Национальное исследование по загрязнению образцов крови в Великобритании
Неустановленное загрязнение образцов крови может иметь множество неблагоприятных последствий для пациентов..
Орозомукоид и эффективность терапии при депрессии
Орозомукоид обладает рядом важных физиологических свойств. Было доказано, что АГП может выступать в роли регулятора сосудистой проницаемости..
Анемия у ребенка. Профилактика и лечение

В современных условиях достаточно трудно найти качественные продукты, содержащие в своем составе все необходимые для растущего организма вещества. В добавок к этому большинство беременных и кормящих матерей не питаются должным образом, цельное коровье молоко слишком рано вводится в рацион ребенка. Все это приводит к тому, что диагноз железодефицитная анемия ставится практически каждой беременной женщине и множеству детей в раннем возрасте. Как же решить эту проблему? Ведь лекарства от анемии могут вызывать различные нарушения стула, аллергические реакции и так далее, а само заболевание отрицательно сказывается на самочувствии и развитии ребенка.
Профилактика железодефицитной анемии
Так как проблема недостатка железа в организме — это в большей степени проблема питания, основная мера профилактики патологии заключается в обеспечении сбалансированного рациона (вне зависимости от возраста человека). Взрослым необходимо 1-2 мг железа в сутки, детям от 0,5 до 1,2. Необходимо отметить, что в кишечнике всасывается лишь часть потребляемого с пищей железа — примерно 10-15%.
Главный источник железа из пищи — продукты животного происхождения. Самыми ценными в этом плане являются говядина и баранина. В рыбе, курице и твороге содержание железа значительно меньше. Важно не только количество вещества в продукте, но и его биодоступность (то есть всасываемость). В отличие от продуктов животного происхождения, растительная пища имеет более низкий уровень всасываемости железа. Для хорошей всасываемости необходимы определенные факторы. Так, например, витамин C улучшает показатели всасываемости железа, а тининовая кислота (содержится в чае) или фитаты значительно снижают степень всасываемости микроэлемента.
Рассмотрим основные рекомендации по профилактике дефицита железа, опубликованные Американской академией педиатрии:
1. У здорового доношенного ребенка в первые 4 месяца жизни имеется достаточный запас железа, и в употреблении железосодержащих лекарств нет необходимости. Затем ребенку на грудном вскармливании необходим дополнительный прием железа вплоть до введения прикорма. Дозировка препарата в этом возрасте должна составлять 1 мг на 1 кг веса в день.
2. Если здоровый доношенный ребенок находится на смешанном типе вскармливания (материнское молоко составляет около 50%), ему необходим дополнительный прием железа в дозировке 1 мг на 1 кг веса в день. Длительность приема — до введения прикорма.
3. При искусственном вскармливании рекомендуется давать ребенку смеси, обогащенные железом. В таком случае необходимость дополнительного приема препаратов не потребуется. При этом, цельное коровье молоко не рекомендуется давать детям в возрасте до года!
4. Детям с 6 месяцев и до года необходимо употреблять около 11 мг железа в сутки. Чтобы обеспечить нормальное функционирование организма, в ранний прикорм следует вводить красное мясо и овощи, содержащие большое количество железа. При недостаточном потреблении таких продуктов ребенку назначаются железосодержащие капли или сиропы.
5. От года до 3 лет суточная норма железа составляет 7 мг. При этом рекомендуется получать его из тех продуктов, которые содержат и железо, и витамин C.
6. Дети, рожденные раньше срока, должны в обязательном порядке получать минимум 2 мг железа на 1 кг веса в сутки до наступления 12 месяцев.
Отметим, что содержание мяса в рационе является лишь профилактикой анемии, если у ребенка уже диагностировалась патология, с ней можно бороться исключительно препаратами железа! Однако если анемии на данный момент не выявлено, то пить железо в качестве профилактики нецелесообразно.
Лечение железодефицитной анемии
Самой главной задачей при лечении анемии является устранение причины ее возникновения (режим питания, обнаружение и ликвидация источников кровопотери и др.), а также борьба с нехваткой железа в организме.
К основным положениям лечения заболевания относятся:
1. Употребление лекарственных железосодержащих препаратов. Иных способов восстановления нормального уровня микроэлемента на данный момент не изобретено. Не стоит ошибочно полагать, что только одной диетой удастся поднять уровень гемоглобина в крови. Запасы железа надо пополнять целенаправленно.
2. Прием пероральных препаратов. Лечение при помощи внутримышечных или внутривенных инъекций рекомендуется лишь при наличии противопоказаний к приему пероральных средств или если они оказались малоэффективны.
3. Предварительный расчет дозировки препарата в соответствии с массой тела ребенка и выбранной тактикой лечения анемии.
4. Расчет длительности приема железа в зависимости от тяжести заболевания. Легкая степень — 3 месяца, средняя — 4,5, тяжелая — полгода. В процессе лечения контролируется общеклинический анализ крови.
5. Восполнение запасов микроэлемента в так называемом «депо железа».
6. Регулярный контроль эффективности лечения при помощи сдачи анализов крови.
В нашей стране тактику лечения анемии определяет Протокол ведения больных с диагнозом «Железодефицитная анемия», который был опубликован в 2004 году. Также имеются соответствующие рекомендации ВОЗ, базирующиеся на принципах доказательной медицины.
На сегодня существует лишь два препарата железа:
1. На основе солевых растворов. Препарат токсичен, нередко вызывает побочные эффекты. Однако встречаются случаи, когда помогает только он.
2. На основе полимальтозного комплекса гидроксида. Наиболее целесообразен при лечении анемии.
Современные исследования показывают, что у лекарственных средств первой и второй группы одинаковая степень эффективности. В педиатрии детская дозировка средств второго типа составляет 5 мг на 1 кг веса в сутки (независимо от возраста ребенка).
Критерии эффективности терапии при анемии
1. На 7-10-е сутки с начала терапии уровень ретикулоцитов начинает повышаться.
2. Концентрация гемоглобина повышается к концу 4-й недели на 10 г/л. Гематокрит увеличивается на 3% в сравнении с первоначальными данными.
3. Спустя 1-1,5 месяца приема препаратов исчезают клинические проявления дефицита железа.
4. «Депо железа» восстанавливается спустя 3-6 месяцев (в зависимости от степени заболевания). Оценивать уровень необходимо по показателям сывороточного ферритина (более 30 нг/мл).
В случае, если спустя 4 недели результаты анализа крови не изменяются, необходимы остановка лечения и пересмотр диагноза. В ряде случаев у таких пациентов имеется не железодефицитная анемия.
При возникновении устойчивости к лечению железосодержащими препаратами следует проверить адекватность назначенной терапии. Может быть анемия не связана с дефицитом железа. Для этого требуется дополнительная консультация детского гематолога.
Читайте также:
